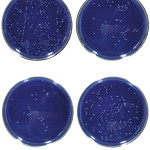
Confronto tra le proprietà antibatteriche di nuove resine composite arricchite con ossido di zinco, acido urosolico e chitosano

Restauro conservativo diretto di un incisivo centrale fratturato
Riassunto
Negli ultimi anni sono state messe a punto tecniche avanzate di odontoiatria adesiva e ricostruttiva che permettono di ricostruire con successo elementi dentari gravemente...
Correlazione tra la morfologia canalare e le dimensioni del perno in fibra nella ricostruzione...
Niccolò Coccoli
Nicola Barabanti
Lorenzo Madini
Pier Antonio Acquaviva
Daiana Don
Antonio Cerutti
Università di Brescia, Insegnamento di Odontoiatria Restaurativa
Titolare: Prof. Antonio Cerutti
Riassunto
La letteratura scientifica mostra che un dente trattato...
L’invecchiamento dentale e lo sbiancamento professionale: valutazione oggettiva allo spettrofotometro
• Loredana Bellia1
• Giuseppe Fiorentino
• Bruno Fontebasso
• Roberta Vuoso
• Michele Nicolò2
1Direttore delle Attività Didattiche del Corso di Laurea in Igiene Dentale - Università degli...
Sbiancamenti dentali laser assistiti con laser a diodi (810-980 nm)
Riassunto
Il sorriso è di particolare interesse per un gran numero di persone che richiedono cure odontoiatriche, e il colore dei denti riveste una notevole...
Riabilitazione estetica conservativa del gruppo frontale superiore
• Federico Berton1
• Milena Cadenaro1
• Roberto Di Lenarda1
1Clinica Odontoiatrica e Stomatologica, Università degli Studi di Trieste
Direttore: prof. Roberto Di Lenarda
Riassunto
L’utilizzo di materiali altamente performanti...
Gli effetti dell’ossigeno sulla polimerizzazione del composito e accorgimenti per contrastarlo
Valutazione dell’inibizione ossidativa e del grado di adesione delle resine composite
Oxygen inhibition and incremental layer bond strengths of resin composites
Shawkat E, Shortall A, Addison...
Protocolli operativi e di controllo per massimizzare il successo nelle situazioni cliniche...
Riassunto
Nel presente lavoro vengono descritti dei protocolli operativi per poter affrontare con sufficiente sicurezza casi clinici avanzati, come il carico immediato, la rigenerazione ossea...
Restauro conservativo diretto di un incisivo centrale fratturato
Riassunto
Un giovane paziente quindicenne si è presentato alla nostra attenzione con una frattura coronale non complicata secondo Andreasen a carico dell’elemento 3.1, in assenza di sintomatologia...
Terapia della polpa vitale: vantaggi dell’utilizzo della tecnologia laser
Riassunto
La conservazione della vitalità pulpare è un trattamento di confine tra terapia conservativa ed endodontica che consente di mantenere l’integrità biomeccanica dell’elemento dentale; l’importanza...
Conservazione della vitalità pulpare in dente con riassorbimento radicolare. Un caso complesso
Il presente caso clinico riguarda un paziente maschio di anni 37 che presenta l’elemento 2.1 con riassorbimento invasivo
extra-canalare sopraosseo1,2, anche classificato come riassorbimento infiammatorio...
Frattura corono-radicolare: gestione di un caso clinico
Riassunto
Per definizione, le fratture corono-radicolari coinvolgono lo smalto, la dentina e il cemento. Si presentano raramente, con una frequenza del 5% in dentizione permanente...
Il restauro estetico degli incisivi centrali con faccette adesive: quale scelta?
Quando impiegare soluzioni totalmente additive tipo no-prep e quali parametri utilizzare per valutarne la praticabilità? È quanto chiede Francesco De Angelis, odontoiatra che esercita...
Effetto in vivo di due sistemi di sbiancamento professionali
Milena Cadenaro1
Lorenzo Breschi1
Cesare Nucci2
Francesca Antoniolli1
Erika Visintini1
Carlo Prati2
Bruce A. Matis3
Roberto Di Lenarda1
1Università degli Studi di Trieste, Dipartimento di Biomedicina Direttore: prof.ssa Paola Narducci
2Università di Bologna “Alma...
VPT e odontoiatria conservativa su denti permanenti
Come gestire una esposizione cariosa in presenza di pulpite reversibile
VTP and conservative dentistry in permanent teeth. How to approach to a carious exposition in...
Il trattamento di lesioni cariose non cavitate tramite infiltrazioni di materiali resinosi
La gestione della carie dentale è cambiata drasticamente negli ultimi anni, evolvendosi dal tradizionale concetto di trattamento e improntandosi sempre più alla prevenzione e...
Confronto tra le proprietà antibatteriche di nuove resine composite arricchite con ossido di zinco,...
Le carie dentali sono le più frequenti malattie del cavo orale, caratterizzate dalla demineralizzazione dei tessuti duri causata dalla produzione di acidi conseguente alla...